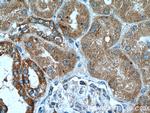
RNF135 Antibody in Immunohistochemistry (Paraffin) (IHC (P))

Search
Proteintech
RNF135 Polyclonal Antibody
{{$productOrderCtrl.translations['antibody.pdp.commerceCard.promotion.promotions']}}
{{$productOrderCtrl.translations['antibody.pdp.commerceCard.promotion.viewpromo']}}
{{$productOrderCtrl.translations['antibody.pdp.commerceCard.promotion.promocode']}}: {{promo.promoCode}} {{promo.promoTitle}} {{promo.promoDescription}}. {{$productOrderCtrl.translations['antibody.pdp.commerceCard.promotion.learnmore']}}
产品信息
25061-1-AP
种属反应
宿主/亚型
分类
类型
抗原
偶联物
形式
浓度
规格
纯化类型
保存液
内含物
保存条件
运输条件
产品详细信息
Immunogen sequence: MAGLGLGSA VPVWLAEDDL GCIICQGLLD WPATLPCGHS FCRHCLEALW GARDARRWAC PTCRQGAAQQ PHLRKNTLLQ DLADKYRRAA REIQAGSDPA HCPCPGSSSL SSAAARPRRR PELQRVAVEK SITEVAQELT ELVEHLVDIV RSLQNQRPLS ESGPDNELSI LGKENSWKPR LPPHAHCLTR ATLHSGELLG LLSGPSIQPL T (1-210 aa encoded by BC005084)
靶标信息
The protein encoded by RNF135 contains a RING finger domain, a motif present in a variety of functionally distinct proteins and known to be involved in protein-protein and protein-DNA interactions. This gene is located in a chromosomal region known to be frequently deleted in patients with neurofibromatosis.
仅用于科研。不用于诊断过程。未经明确授权不得转售。
生物信息学
蛋白别名: E3 ubiquitin-protein ligase RNF135; MGC13061; REUL; RIG-I E3 ubiquitin ligase; RING finger protein 135; RING finger protein leading to RIG-I activation; RING-type E3 ubiquitin transferase RNF135; Riplet; U 2-3-0; unnamed protein product
基因别名: 0610037N03Rik; 2410006N06Rik; L13; MMFD; REUL; Riplet; RNF135
UniProt ID: (Human) Q8IUD6, (Mouse) Q9CWS1
Entrez Gene ID: (Human) 84282, (Mouse) 71956